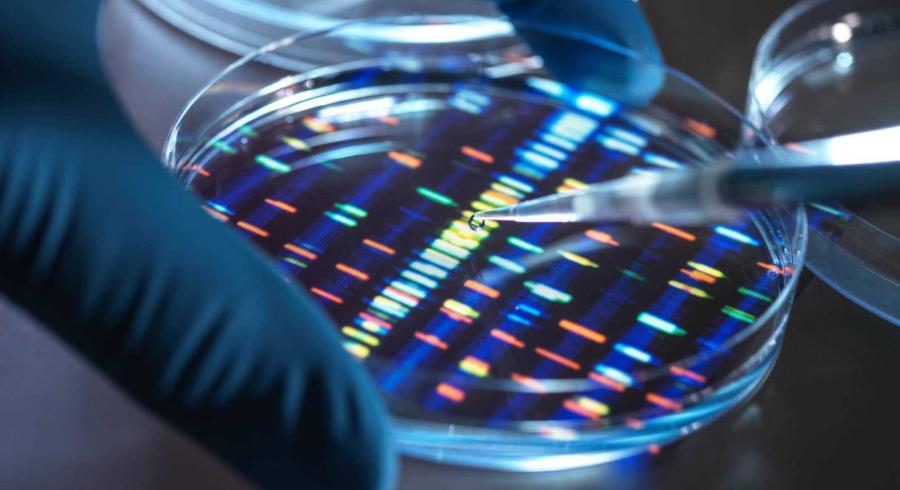

Aunque aún se encuentra en fase clínica, los resultados son esperanzadores, ya que según los datos de su ensayo en fase 2, esta vacuna experimental, en combinación con la inmunoterapia.
Conoce más en: https://www.rtve.es/noticias/20230419/vacuna-arn-mensajero-moderna-melanoma/2439132.shtml